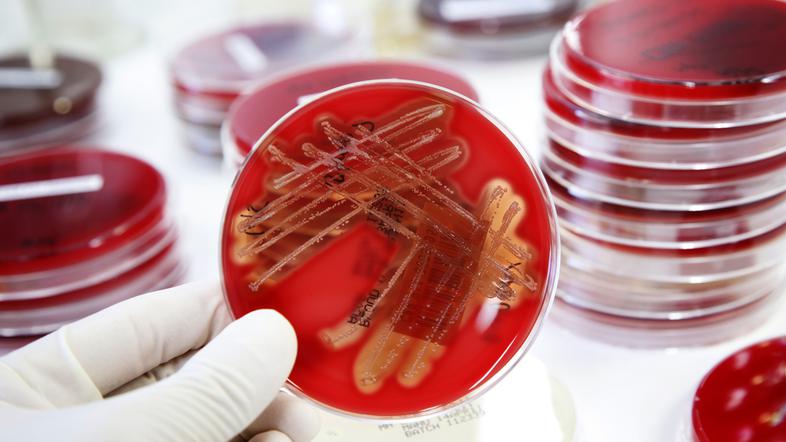
Bakterije

"Odpornost proti antibiotikom narašča, nam pa zmanjkuje možnosti zdravljenja," je dejala predstavnica WHO, odgovorna za inovacije Marie-Paule Kieny.
Farmacevtska podjetja si namreč ne želijo raziskovanja novih antibiotikov in to zaradi bojazni, da bi tudi morebitna nova zdravila kmalu postala neučinkovita: "Če to prepustimo trgu, novi antibiotiki, ki jih nujno potrebujemo, ne bodo pravočasno razviti," je opozorila. Svetovna zdravstvena organizacija zato vlade poziva k spodbujanju javnih ustanov in podjetij, katerih prioriteta naj bo v razvoju novih antibiotikov.
Sicer je WHO prvič do sedaj objavila seznam bakterij, ki so odporne na več zdravil in predstavljajo veliko tveganje za zdravje. Razdelili so jih v tri kategorije nujnosti potrebe po novih antibiotikih in sicer na kritične, visoke in srednje pomembne:
Na vrh seznama se uvrščajo tako imenovane "gram-negativne" bakterije, ki so dokazano odporne na večino zdravil.
Bolnišnične okužbe
Gre za bakteriji Acinetobacter baumannii in Pseudomonas aeruginosa, ki se ju povezuje z bolnišničnimi okužbami in to v okoljih, kjer poteka zdravstveno varstvo, kot so domovi za ostarele in onemogle ljudi. Običajno se pojavijo pri ljudeh, ki potrebujejo ventilatorje ali žilni kateter.
Med najbolj kritične WHO uvšča Enterobacteriaceae, kamor spadata tudi E. coli in klebsiella: "Te bakterije so odgovorne za visoko stopnjo umrljivosti," je povedala Marie-Paule Kieny.
V kategorijo bakterij, ki po vedenju strokovnjakov postajajo vedno bolj odporne na zdravila, spadajo bakterije spolno prenosljive gonoreje, salmonele, ki se prenaša s hrano, in šigele, visoko infektivne bakterije, ki povzročajo krvavo drisko.
Umre 700 tisoč ljudi na leto
V svetovnem merilu je odpornost na antibiotike prisotna v vsaki državi, WHO pa ocenjuje, da zaradi superbakterij letno na globalni ravni umre 700 tisoč ljudi. Če ne bo odločnih ukrepov, lahko pričakujemo, da bo do leta 2050 zaradi superbakterije deset milijonov smrti na leto, so zapisali.
Tuberkoloza med prednostnimi nalogami
Tuberkuloze, ki je ravno tako bakterijska bolezen in je ravno tako vedno bolj odporna; nekatere države že poročajo o prvih primerih absolutne odpornosti, sicer ni na seznamu, saj spada v posebno področje raziskav in razvoja. Se pa WHO strinja, da jo je treba uvrstiti med prednostne naloge raziskav novih antibiotikov.
dezurni@zurnal24.si